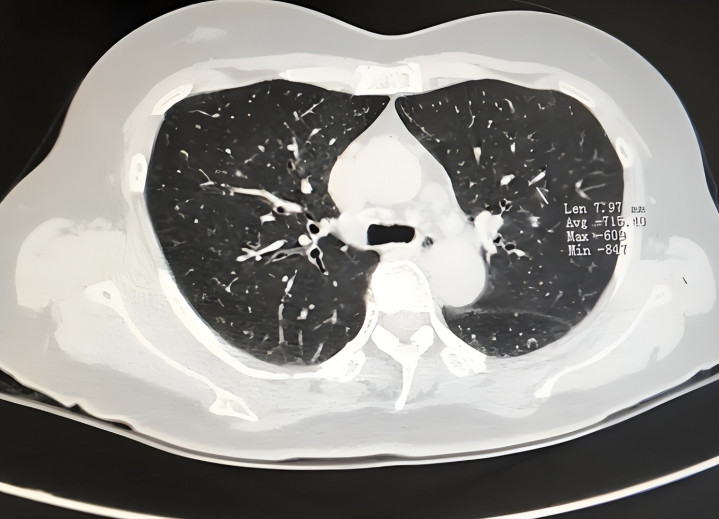

开云资讯
开云体育官方网站 肺部运行病变, 不是看咳不咳嗽! 提醒: 若出现6个特别或也曾病变


“我又不咳嗽,肺怎么会有事?”
58岁的老周在体检中心门口这样说时,口吻很详情。闲居他不抽烟、不伤风,偶尔爬楼会喘,他只当“年岁到了”。直到一次单元低剂量胸部CT,诠释领导肺部小结节并伴轻度肺气谈改动,他才呆住:蓝本肺部问题,并不总所以咳嗽开场。

这不是为了吓东谈主,而是好多东谈主齐会踩的阐述误区。肺部早期病变经常“静暗暗”,咳嗽、咳痰或然反而出当今更靠后的阶段。果真好得警惕的,是那些被忽略的“小特别”:比如活动后气短、握续胸闷、声息变化、反复低热等。
问题在于,这些信号很容易被当成“累了”“上火了”“没睡好”。比及拖成知晓症状,惩办难度就上来了。今天这篇著述就说了了:肺部病变早期,身段可能发出的6个提醒,以及哪些东谈主更该尽早筛查、怎么作念更稳妥。
好多东谈主以为,肺有问题=先咳嗽。其实从呼吸科门诊教学看,咳嗽仅仅施展之一,不是“惟一开关”。
肺组织自身痛觉神经散播少,早期局灶改动可能并不引起知晓难受或剧烈咳嗽。尤其是部分肺结节、早期肺癌、轻度慢阻肺改动,可能在一段技艺内症状并不典型,更多通过影像学发现。

从指南共鸣看,肺部疾病早发现依赖两件事:识别非典型特别 + 实时作念模范检讨(如低剂量螺旋CT、肺功能等)。尤其是年龄增长、有抽烟史或永久油烟/粉尘露馅的东谈主群,更不可只盯着“咳没咳”。
要是出现以下6个特别,开运体育中国官网入口提出提高警惕,不要自行永久不雅察:
胸闷、气短比夙昔更知晓
夙昔上3层楼不而已,当今上1层就要停一下;或走平路言语时容易“接不上气”。这种变化若握续率先2—4周,要排查肺功能和心肺情景。
深呼吸时胸部或背部隐秘
不是每次齐痛,可能一阵一阵,吸气时更知晓。部分胸膜受累、炎症或局部病灶围聚胸膜时,会出现这类施展。短期反复出现,不提出硬扛。

久拖不愈的“幽微咳”或清嗓子
有些东谈主不是剧烈咳嗽,而是干咳、晨起咽部不适、总念念清嗓,握续3周以上,尤其伴有乏力、体重波动时,开云体育需就诊明确原因。
痰中带血丝或铁锈色痰
哪怕量少、偶发,也不可薄情。感染、支气管延迟、肿瘤等齐可能出现该信号。出现一次就该就医,不要等“下次再说”。
反复低热、冷汗、体重下落
莫得知晓伤风,却反复低热,夜间出汗增多,近1—3个月体重不解原因下落(如下落≥5%),领导体内可能有慢性炎症或其他特别经过。

声息沙哑、永久疲困且收复慢
部分胸部病变可曲折影响喉返神经或举座呼吸效果,施展为讲话易累、声息变粗哑、全天乏力。若握续存在,应排查呼吸系统问题。
看到特别后,最庞大的是“怎么作念”,而不是我方吓我方。可参考这套实用作念法:
先作念基础评估,再决定复查节律
到正规病院呼吸科就诊,勾通病史、体格检讨,按需选择低剂量胸部CT、肺功能、血旧例及炎症观念。不要一上来就反复拍片,也不要永久不查。
高风险东谈主群把筛查作念在前边
一般合计,年龄偏大且有永久抽烟史、干事粉尘露馅、肺癌家眷史者,应喜爱年度筛查。对部分高风险东谈主群,模范的低剂量CT可擢升早期发现率。

居家环境别忽略“隐形刺激源”
永久霉菌、厨房油烟、装修粉尘、刺激性清洁剂蒸发,齐可能加多呼吸谈职责。保握透风、减少高温爆炒、模范使用清洁消毒居品,齐是“护肺小事”。
戒烟和通顺,是性价比最高的干扰
任何阶段戒烟齐不晚。规定有氧通顺(如快走)每周累计150分钟以上,以“能言语但不可唱歌”的强度为宜,有助于擢升心肺耐力。
别把“结节”径直等同于“癌”
肺结节是影像学描写,不是最终会诊。宽绰小结节需按大夫提出随访不雅察,重心看大小、旯旮、密度及动态变化。过度战栗和有余放任齐不可取。
说到底,肺部病变最怕两件事:一是有余没封闭,二是过度战栗张检讨。果真科学的作念法,是识别特别信号、实时模范就医、按决议随访。好多问题在早期是有契机踏实狂放甚而精致惩办的。
本文为健康学问科普,勾通泰斗贵府和个东谈主不雅点撰写,部分情节为浮浅抒发和阅读聚积进行了妥当造谣与润色,现实仅供参考,不可替代大夫会诊。如感不适,请实时就医。保藏以备器二不匮,转发给你暖热的东谈主!
参考贵府:
《中国住户膳食指南(2022)》
《中国成东谈主肺癌筛查与早诊早治指南》
《原发性肺癌调治指南(2024年版)》开云体育官方网站
AG百家乐APP官方网站
备案号: